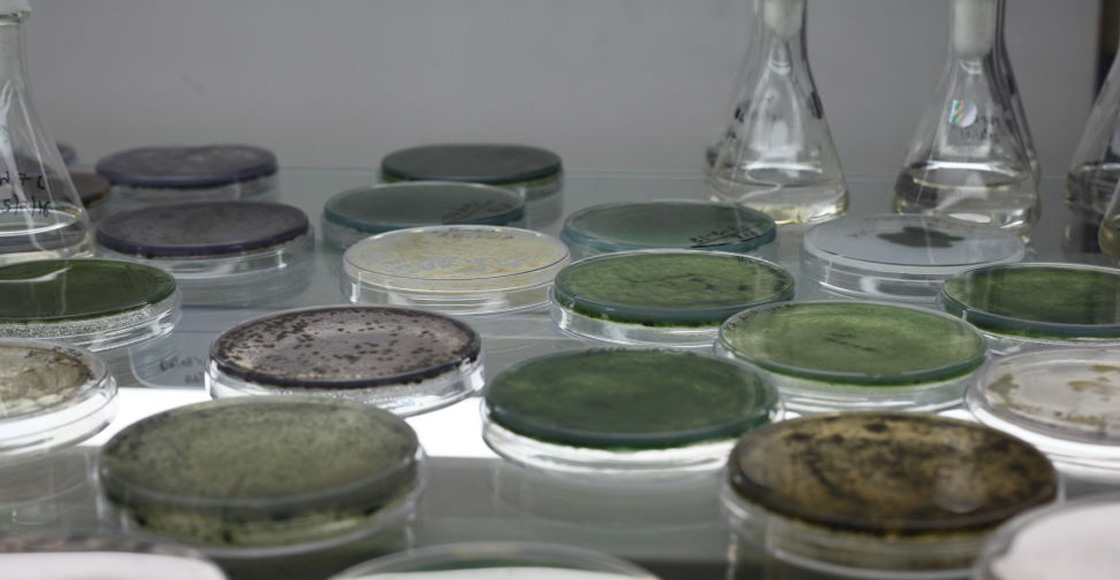

Mucho ojo con esta información. Recientemente se publicó un estudio que demuestra que en tres años aumentaron considerablemente los casos Candida auris en Estados Unidos.
Y no es lo más preocupante: el número de casos de este hongo que fueron resistentes a los medicamentos que se ocupan para su tratamiento aumentaron considerablemente.
¿Qué es lo que está pasando con el hongo Candida auris?
El estudio, publicado por especialistas de los Centros para el Control y la Prevención de Enfermedades de Atlanta, en Georgia, explica que Candida auris es una amenaza fúngica emergente que se ha estado propagando en Estados Unidos desde que se informó por primera vez en 2016.
Entre 2019 y 2021 se informaron 3 mil 270 casos clínicos y 7 mil 413 casos de detección de ese hongo.
Por ejemplo, en 2019 se registró un aumento del 44% en los casos detectados pero para 2021 el aumento fue del 95%.

Y por si no fuera poco, resulta que el número de casos de Candida auris que fueron resistentes a los medicamentos que se usan para su tratamiento en 2021 fueron 3 veces más que en los años anteriores.
“Estos hallazgos resaltan la necesidad de mejorar las prácticas de detección y control de infecciones para prevenir la propagación de C. auris“, se lee.
Pero ¿qué es el Candida auris?
El Candida Auris es un tipo de hongo que puede causar una infección grave. Generalmente se propaga en centros de atención médica como hospitales.
Una vez que el hongo entra al cuerpo puede ocasionar una infección grave en la sangre y los órganos, generalmente a personas que tienen un sistema inmune debilitado. Las personas con sondas de respiración o alimentación tienen más alto riesgo de infección.
Hay personas que portan este hongo sin saberlo y sin enfermarse, personas que son portadoras. Es decir, pueden contagiarlo a otras personas y tienen riego de desarrollar la infección en el futuro.

La cosa es que frecuentemente es un hongo multirresistente. Los medicamentos antimicóticos que comúnmente se usan para tratar otras infecciones por Candida casi no tienen efecto en la auris.
Es más, algunas cepas aisladas del hongo son resistentes a las 3 principales clases de medicamentos antimicóticos.
Algunas personas que están en riesgo alto de infección, por ejemplo, tienen afecciones médicas anteriores, se sometieron a una cirugía o toman antibióticos/antimicóticos con frecuencia.